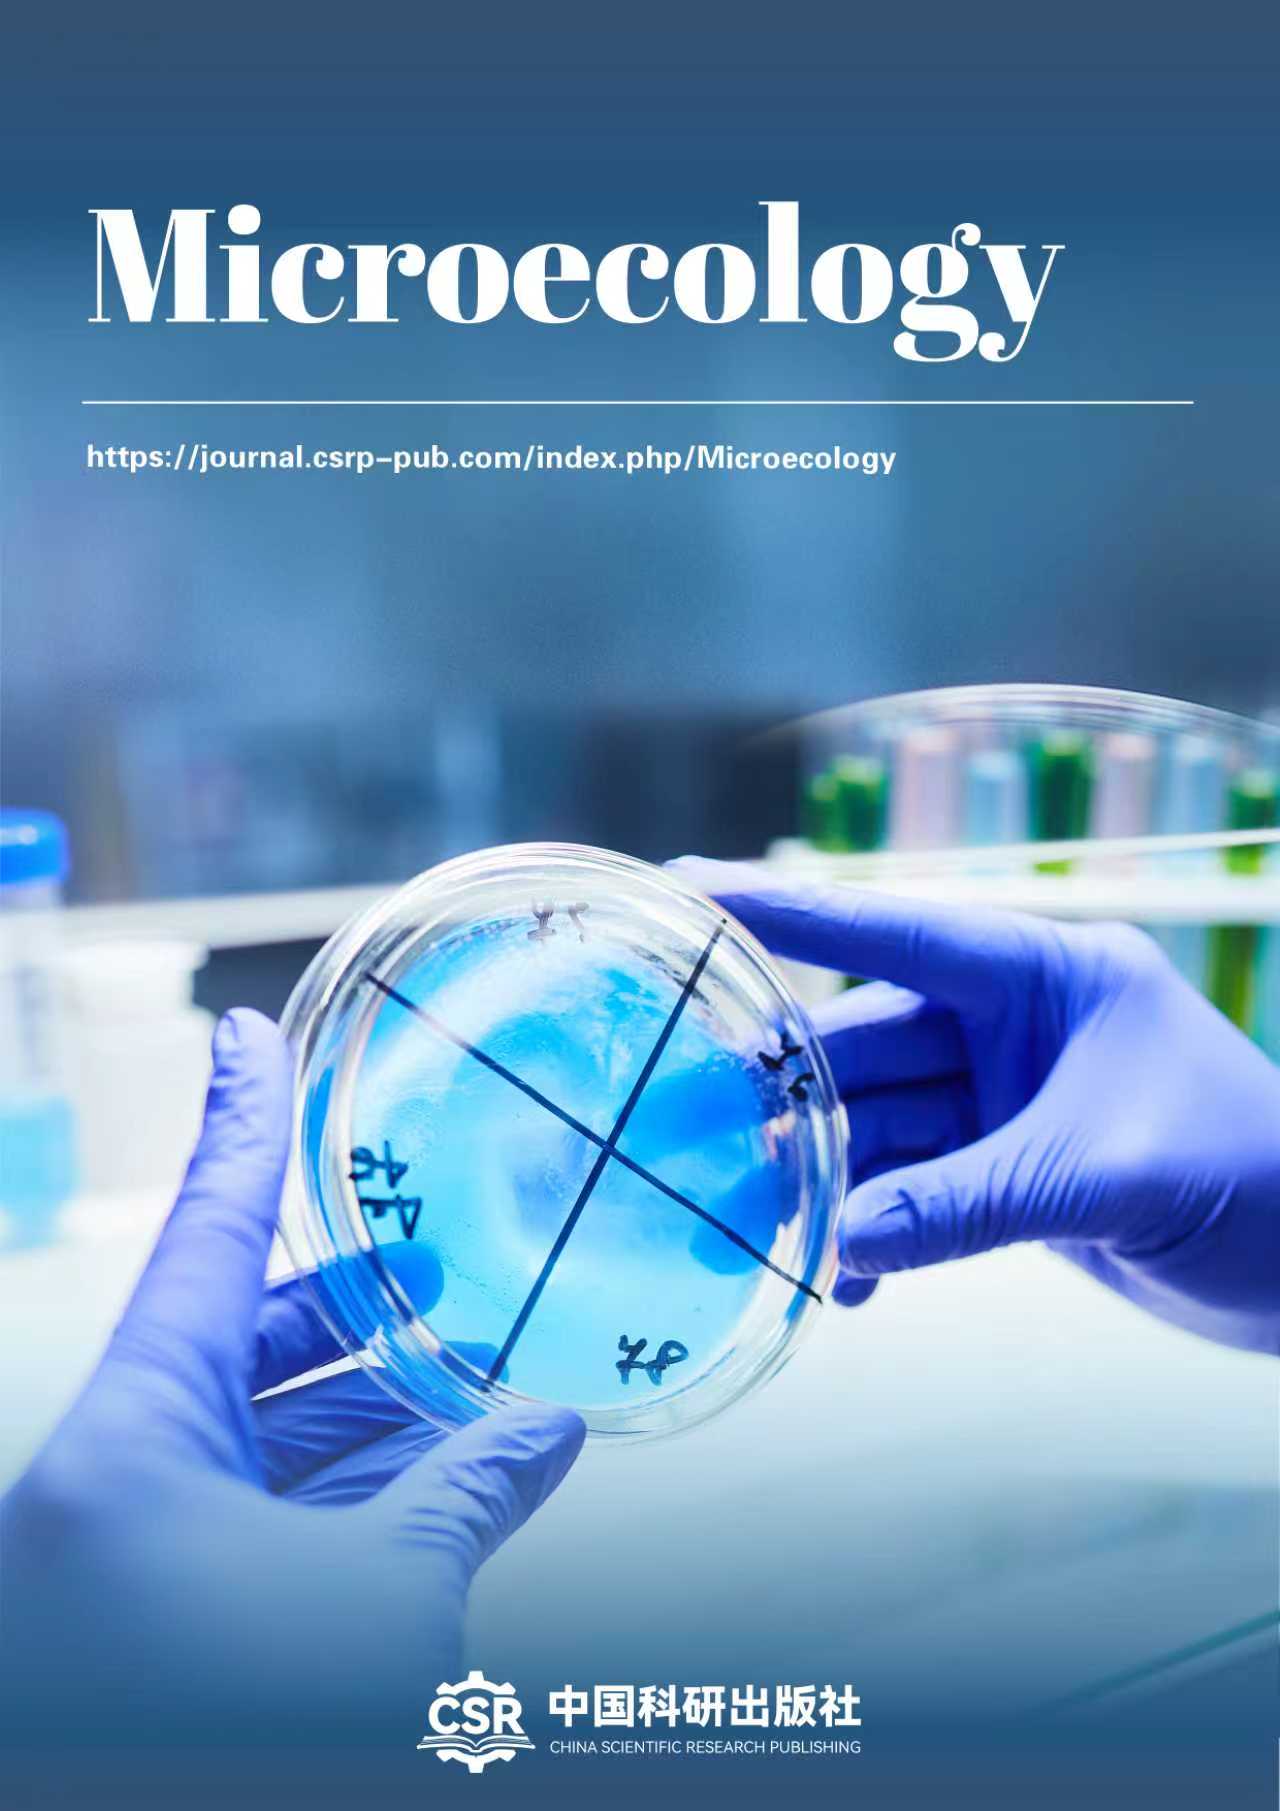
Journal cover

China Scientific Research Publishing, established in 2025 in Asia's world city, has carved a unique niche as the premier gateway to Chinese scholarship for the global academic community. Our distinct mission is to curate and elevate China's premier research onto the world stage。
Our unique model is built on being a "Bicultural Academic Gateway". We masterfully bridge two worlds: we operate a portfolio of high-impact international journals that showcase cutting-edge Chinese research in fields like materials science, integrative medicine, and AI, ensuring it meets global standards of excellence. Simultaneously, we leverage deep local expertise to publish authoritative works and host conferences that illuminate the context and innovation behind China's scientific achievements.
More than a publisher, we are a cultural and academic interpreter. We provide the essential platform for dialogue, enabling global scholars to not just access but truly engage with China's scientific progress, fostering a truly integrated and collaborative global research ecosystem.
Journals
-
Journal of Policy and Society
Journal of Policy and Society (JPS) is a fully open access peer-reviewed journal covering a broad range of topics in Public Policy and Administration. It publishes themed sections that encourage in-depth, critical analyses of specific policy areas. The journal welcomes scholarly papers - both theoretical and empirical - which analyse any aspect of social policy and its relationships with society from different angles. Contributions on teaching and learning issues within the discipline are also welcome.
-
Global Population Perspectives
Global Population Perspectives (GPP, eISSN: 3135-1352) is an online double-blind, peer reviewed, open access journal concerned with population studies. GPP aims to delve into the complexities of global population dynamics and their impacts on society, economy, and environment. It will cover a wide array of topics including population growth, migration, aging, fertility rates, and mortality rates. Please refer to the Focus and Scopes of the journal for more details. We welcome diverse forms of research, including original research articles, reviews, theoretical studies, empirical analyses, case studies, and policy evaluations, especially those providing innovative perspectives and practical solutions.
-
Microecology
Microecology is an international, peer-reviewed journal that focuses on the field of microbial ecology. The journal publishes original research, reviews, methodological papers, and short communications that explore the interactions between microorganisms and their environments, other organisms, and hosts. The primary aim of Microecology is to advance the understanding of the role microorganisms play in ecosystem functioning, ecological stability, and biogeochemical cycles. The journal also emphasizes how microbial communities contribute to human health, agriculture, environmental sustainability, and biotechnology.
-
Literature Forum
Literature Forum (LF) is an international, peer-reviewed, open access journal on literature and cultural studies. LF aspires to bring together scholars interested in developing the research of literature, and to provide the most suitable environment for contributions from all the world's literary traditions. The journal welcomes submissions that can concurrently imagine any literary tradition, moving beyond national frames to simultaneously discuss and develop the cosmopolitan threads of a variety of literary traditions.
-
Large Models and Embodied Intelligence
Large Models and Embodied Intelligence is an open-access journal dedicated to advancing frontier research in large-scale models and embodied intelligence. The journal aims to promote the paradigm shift of artificial intelligence from static perception and reasoning toward an integrated framework encompassing perception, cognition, decision-making, action, and interaction. The journal focuses on the deep integration of large foundation models, intelligent agents, and physical-world interaction, with an emphasis on autonomy, generalization, and safety in real-world or high-fidelity environments. It covers theoretical foundations, model architectures, learning paradigms, system implementations, and practical applications of embodied intelligence, and encourages original contributions that bridge artificial intelligence, robotics, control, cognitive science, and human–computer interaction. Large Models and Embodied Intelligence welcomes high-quality original research article, review, perspective, commentary and more types. The journal emphasizes both methodological innovation and validation in real-world settings, addressing key challenges toward general-purpose embodied intelligence.
Topics of interest include, but are not limited to:
- Large-scale pre-trained models (LLMs, VLMs, VLAs)
- Embodied agents and multi-agent systems
- Multimodal embodied perception and spatiotemporal understanding
- Embodied manipulation and control
- Embodied navigation and motion planning
- Embodied world models and causal reasoning
- Reinforcement learning and imitation learning
- Embodied autonomous and lifelong learning
- Human–robot interaction and collaboration
- Collective and swarm embodied intelligence
- Applications of Large Models
- Safety, trustworthiness, and ethics of embodied intelligence
-
Psycho-Environmental Sustainability
Psycho-Environmental Sustainability (PES) is an international, interdisciplinary, open-access academic journal that bridges psychology, environmental science, social sciences, and the humanities. We focus on the dynamic interplay between human psychology—cognition, emotion, motivation, and behavior—and environmental sustainability challenges. Our mission is to publish high-quality research that advances theoretical understanding while providing empirical foundations for policy-making, business practice, and community action, thereby fostering the transition toward a sustainable future.
-
Progress in Environmental Chemistry
The Progress in Environmental Chemistry is a premier international forum dedicated to the rapid dissemination of high-impact research at the forefront of environmental chemistry. The journal publishes original research articles, critical reviews, and perspectives that address pressing environmental challenges and advance our understanding of chemical processes in the environment. We are committed to promoting innovative solutions for a sustainable future.
-
Bio-Herbicides and Sustainable Weed Management Journal
Bio-Herbicides and Sustainable Weed Management Journal (BHSWMJ) focuses on research related to biological weed control, particularly the development and application of plant- and microbe-derived herbicides. It is intended to attract submissions on allelopathy, phytochemicals with herbicidal properties, sustainable weed-control strategies and eco-friendly alternatives to synthetic herbicides. The journal will serve researchers working on natural-product discovery, weed resistance issues and environmentally responsible weed management. Its strength lies in addressing the global need for safer, sustainable herbicide solutions and providing a dedicated platform for innovation in bio-herbicide development.
-
Advanced Manufacturing, Materials Engineering and Process Innovation
Advanced Manufacturing, Materials Engineering, and Process Innovation (AMMEPI) aims to advance manufacturing science through innovative materials processing and modern production technologies. It specializes in additive manufacturing, composites, machining, and automated inspection. Its advantages lie in its extensive engineering expertise and the interdisciplinary integration of materials science and manufacturing.
-
Smart Grid Power Systems and Intelligent Energy Networks
Smart Grid Power Systems and Intelligent Energy Networks (SGPSIEN) specialises in cutting-edge smart grid innovation, integrating renewable energy, distributed systems, power electronics, and AI-driven optimisation to support global energy transition. Its core strength lies in bridging advanced grid architecture with real-time digital monitoring, cybersecurity, and digital-twin–enhanced simulation. As countries modernise their power infrastructure and accelerate electrification, research on microgrids, EV charging integration, and grid resilience is rapidly expanding. The journal fulfils a critical publication gap by offering a comprehensive platform for engineers, researchers, utilities, and policymakers. Its multidisciplinary scope ensures high submission volume, strong citation potential, and strategic relevance for Web of Science indexing.
-
Circular Economy, Resource Efficiency and Sustainable Production
Circular Economy, Resource Efficiency and Sustainable Production (CERESP) focuses on circular economy and sustainable production one of the fastest-growing areas in sustainability science. It attracts researchers from engineering, business, materials science, manufacturing, supply-chain management, and environmental policy. The global shift toward net-zero manufacturing, waste reduction, and resource regeneration drives substantial research output, ensuring very high submission volume. Its integration of industrial innovation, behavioural consumption patterns, and policy instruments creates a multidisciplinary platform with strong citation opportunities. This journal’s focus on real-world industrial transformation aligns with global priorities, making it highly competitive for future indexing.
-
Asian Journal of Accounting, Auditing and Financial Ethics
A regionally branded yet globally relevant journal, A regionally branded yet globally relevant journal, Asian Journal of Accounting, Auditing and Financial Ethics (AJAAFE) focuses on ethical practices, integrity frameworks, and transparency in financial reporting. Its unique advantage is integrating accounting, corporate ethics, and auditing, appealing to both academics and practitioners in Asia-Pacific.
-
Circular Polymers and Bio-Based Materials
Circular Polymers and Bio-Based Materials (CPBM) focuses on sustainable polymer science with a direct emphasis on circular material pathways and bio based resources. It integrates biodegradable plastics, biomedical polymer blends, waste valorisation and circular polymer engineering into one coherent platform. Its advantage lies in addressing global priorities such as plastic pollution reduction, renewable material development and the transition to circular economy practices. By covering fundamental chemistry, applied engineering and environmental assessment, the title attracts a wide and active community of materials scientists, environmental engineers, agricultural residue researchers and biomedical polymer developers. The field is fast growing and ensures strong long term submission demand.
-
Intelligent Transportation, Mobility Engineering and Highway Systems
Intelligent Transportation, Mobility Engineering and Highway Systems (ITMEHS) aims to modernise transportation engineering through smart mobility systems and highway innovations. It specialises in intelligent transport systems, pavement engineering, and mobility optimisation. Its advantage is very high international submission from civil, automotive, and ICT sectors.
-
Journal of Soil Health and Environmental Preservation
Journal of Soil Health and Environmental Preservation (JSHEP) focuses on soil health as a foundation of environmental stability, providing a dedicated platform for research linking soil quality, ecological resilience and sustainable land management. It attracts submissions from soil scientists, ecologists, agronomists and environmental researchers studying soil function, degradation processes and preservation strategies.Its advantage lies in addressing global priorities such as carbon sequestration, land restoration, climate resilience and sustainable food production. By integrating soil biology, soil chemistry, conservation practices and environmental protection, the journal supports both scientific innovation and real-world soil-preservation solutions, ensuring strong and continuous research demand.
-
Mechanical Innovation and Sustainable Machine Systems
Mechanical Innovation and Sustainable Machine Systems (MISMS) aims to promote innovative and sustainable approaches in mechanical engineering, focusing on advanced machine design, energy efficiency, and performance optimisation. It specialises in fluid–thermal systems, mechanical dynamics, and eco-efficient machinery. Its advantage lies in the vast global mechanical engineering community and the increasing demand for sustainability-focused mechanical solutions.
-
Journal of Urban Sustainability, Smart Communities and Resilience
Journal of Urban Sustainability, Smart Communities and Resilience (JUSSCR) focuses on the rapidly growing field of sustainable urban development, integrating smart technologies, resilience planning, infrastructure innovation, and community well-being. With global urbanization and climate pressures rising, research in urban systems, mobility, climate resilience, smart cities, and sustainable housing is expanding dramatically. This ensures a very high submission volume from urban planners, engineers, geographers, public health experts, and data scientists. The blend of sustainability, digital governance, resilience, and community-centred research provides a unique interdisciplinary profile that appeals to both academic and policy audiences, supporting strong citation potential and indexing scalability.
-
Low-Carbon Reservoir Engineering and Subsurface Energy Systems
Low-Carbon Reservoir Engineering and Subsurface Energy Systems (LCRESES) focuses on the intersection of subsurface engineering, low‑carbon operations, and energy transition. It publishes cutting‑edge research on CO₂ storage, geothermal recovery, reactive transport, geomechanics, enhanced oil recovery with decarbonisation, monitoring technologies, and coupled THMC modelling. The journal aims to advance safe, sustainable, and economically viable subsurface solutions for net‑zero goals. It serves academic researchers, reservoir engineers, geoscientists, environmental modellers, and energy policymakers, bridging fundamental science with field application and risk governance for long‑term system performance.
-
Journal of Climate Risk, Society and Innovation
Journal of Climate Risk, Society and Innovation (JCRSI) specialises in the fast-growing intersection of climate risk, societal change, and technological innovation. Its broad, interdisciplinary scope attracts researchers from climate modelling, behavioural science, economics, governance, AI, urban planning, and disaster management. By covering both technical tools (AI risk systems, digital twins) and social dimensions (public perception, misinformation, climate justice), the journal captures a wide scholarly audience and remains relevant to global policy debates. The emphasis on climate risk financing, adaptation pathways, and socio-technical resilience aligns strongly with international research funding priorities. This integrated framing ensures high submission volume, strong citation potential, and a clear indexing pathway.
-
Geo-Mechanics, Subsurface Engineering and Slope Stability
Geo-Mechanics, Subsurface Engineering and Slope Stability (GMSESS) aims to promote advanced geotechnical engineering with a focus on subsurface modelling and slope stability. It specialises in soil/rock mechanics, geohazards, and ground–structure interaction. Its advantage is stable demand and relevance to civil, mining, and geoscience communities worldwide.
-
International Journal of Digital Law, Technology and Society
International Journal of Digital Law, Technology and Society (IJDLTS) focuses on the fast-evolving interface between digital law, emerging technologies, and societal transformation. It attracts high-quality submissions from legal researchers, technologists, cybersecurity experts, and digital policy scholars. The journal’s strong emphasis on AI governance, cyber law, fintech regulation, and online platform accountability aligns with modern global priorities. By adding sustainability as a separate category, it expands its reach to include digital equity, ethical technology, and responsible digital development all high-growth research areas.
-
Journal of Community, Public Health and Preventive Nursing
Journal of Community, Public Health and Preventive Nursing (JCPHPN) focuses on nursing roles in community health, public health, and preventive care—areas experiencing rapid expansion due to shifting global health priorities. It attracts submissions from public-health nurses, community practitioners, health educators, epidemiologists, and global-health researchers. By covering maternal–child health, rural care, vulnerable populations, mental health promotion, and disaster preparedness, the journal maintains broad international relevance. Its emphasis on preventive strategies, health promotion, and behaviour change supports strong citation potential and cross-disciplinary collaboration. This makes the journal an essential platform for evidence-based public-health nursing research with high submission volume.
-
Personalized Nutrition and Microbiome Innovation
Personalized Nutrition and Microbiome Innovation (PNMI) focuses on the rapidly advancing field of personalised nutrition and microbiome-based health innovation. Its speciality is combining mechanistic microbiome science with clinical nutrition, biomarker discovery, and digital health technologies—domains traditionally published in separate journals. The advantage lies in offering a central platform for cutting-edge research on personalised dietary interventions, AI-guided nutrition tools, and microbiome-targeted functional foods. The journal is positioned to attract substantial submissions from biomedical labs, clinical researchers, biotech companies, and digital health developers. High citation potential comes from fast-moving microbiome research and strong industry relevance.
-
Quantum Materials and Next-Generation Computing Review
Quantum Materials and Next-Generation Computing Review (QMNGCR) will concentrate on the materials science that underpins quantum and post-CMOS computing technologies. It seeks submissions that bridge condensed-matter physics, materials engineering and device integration, with a special emphasis on review and perspective articles that map out emerging directions. Its advantage is to offer a focused venue for researchers who currently publish in either general materials journals or quantum-information outlets, but lack a dedicated platform at the materials–device interface.
-
Journal of Invasive Plant Biology
Journal of Invasive Plant Biology (JIPB) focuses on the ecology, biology and environmental impact of invasive plant species, offering a platform for studies that explain how invasive plants establish, spread and alter ecosystems. It is intended to attract submissions on invasion mechanisms, ecological consequences, climate-driven invasion patterns and restoration strategies. Unlike journals centred on herbicides or weed management, this journal emphasises ecological processes, species behaviour, evolutionary patterns and environmental risks associated with plant invasions. Its main advantage lies in supporting researchers working on biodiversity loss, ecosystem resilience and invasive-species monitoring, areas that are rapidly growing due to global environmental change and conservation priorities.
-
Journal of Safety Engineering and Risk Control
Journal of Safety Engineering and Risk Control (JSERC) aims to advance engineering solutions that reduce industrial risks and improve operational safety. It specialises in process safety, risk modelling, mechanical safety, and human factors. Its advantage is broad applicability across chemical, civil, mechanical, petroleum, and industrial engineering, ensuring a steady and diverse submission flow.
-
Journal of Business Analytics and Data-Driven Decision Making
Journal of Business Analytics and Data-Driven Decision Making (JBADDM) advances research that strengthens the role of data in organizational strategy, performance, and innovation. The journal publishes studies on business intelligence, predictive analytics, machine learning, and artificial intelligence that enhance managerial judgment and marketing effectiveness. It invites work on decision-support systems, digital transformation, consumer and market analytics, and analytical applications in operations, supply chains, and finance. Contributions addressing ethical, governance, and policy implications of data-driven practices are also encouraged. The journal welcomes methodological, empirical, and applied research that demonstrates how analytics improves decisions across diverse business environments.
-
Green HRM & Sustainable Organizations
Green HRM & Sustainable Organizations (GHSO) serves as an interdisciplinary international platform dedicated to publishing cutting-edge research on green human resource management and its central role in building sustainable organizations. It focuses on the intersection of human resource management, organizational behavior, corporate social responsibility, environmental management, and business ethics. We encourage explorations of the complex interactions between human resource management and environmental sustainability from micro (individual employees), meso (organizational practices), and macro (institutional, national) perspectives, aiming to advance theoretical innovation and provide evidence-based support for management practices.
-
Journal of Environmental Law and Policy
Journal of Environmental Law and Policy (eISSN 2564-016X) is an international, scientific double blind peer-reviewed open access journal.
Open Access: free for readers, with article processing charges (APC) paid by authors or their institutions.
Fast Publication: Provisional acceptance to the submitted article is given in 1 week time. After consent of author(s), manuscript is peer-reviewed, and a first decision provided to authors in 2-4 weeks after submission.
-
Journal of Biological Regulators and Homeostatic Agents
Journal of Biological Regulators and Homeostatic Agents (JBRHA, Print ISSN: 0393-974X, Electronic ISSN: 1724-6083) is a peer-reviewed journal published 4 issues per year since 2025. The journal is committed to publishing the full range of topics in the fields of experimental and clinical medicine, molecular biology, biochemistry, regulatory molecules, cellular immunology and pharmacology and the single most important criterion for acceptance is scientific excellence. The content of the article includes putting forward and verifying some hypotheses, new ideas or new problems to be solved, as well as novel findings from experiment, which will provide new perspectives and methods for understanding these topics, and stimulate the interest of the journal readers.
-
International Journal of Cancer Nursing and Supportive Oncology
International Journal of Cancer Nursing and Supportive Oncology (IJCNSO) is an international, peer-reviewed scholarly journal dedicated to advancing excellence in cancer nursing, caregiver support, education and supportive oncology through holistic, patient-centered, and interdisciplinary approaches.
The journal publishes high-quality research and scholarly work that strengthens evidence-based nursing practice, enhances patient and caregiver outcomes, and promotes innovation in supportive cancer care. IJCNSO embraces a holistic and person-centered approach that recognizes the physical, psychological, social, behavioral, and survivorship dimensions of oncology nursing.
The journal serves as a multidisciplinary platform connecting nurse researchers, oncology clinicians, educators, supportive care specialists, psycho-oncology professionals, and healthcare leaders worldwide.
IJCNSO welcomes clinically meaningful and methodologically rigorous contributions that advance nursing knowledge and improve cancer care delivery globally.